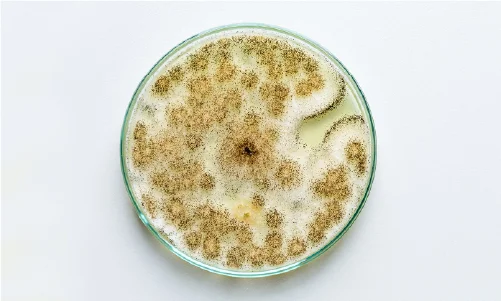
Control microbiologico 1

Ce site web utilise ses propres cookies pour permettre une navigation sécurisée et pour adapter le contenu du site web. Des cookies tiers sont également utilisés pour analyser la navigation des utilisateurs et vous présenter des publicités qui vous intéressent en fonction d'un profil établi à partir de vos habitudes de navigation. Vous pouvez consulter la politique en matière de cookies.
Le stockage ou l'accès technique est strictement nécessaire dans le but légitime de permettre l'utilisation d'un service spécifique explicitement demandé par l'abonné ou l'utilisateur, ou dans le seul but de réaliser la transmission d'une communication via un réseau de communication électronique. Veuillez noter que vous pouvez configurer votre navigateur pour qu'il bloque ces cookies ou qu'il vous en avertisse, mais il est possible que certaines parties du site web ne fonctionnent pas.
Un stockage ou un accès technique est nécessaire dans le but légitime de stocker les préférences non demandées par l'abonné ou l'utilisateur.
Le stockage ou l'accès technique utilisé exclusivement à des fins statistiques.
Stockage ou accès technique utilisé exclusivement à des fins statistiques anonymes. En l'absence de demande, de conformité volontaire de la part de votre fournisseur d'accès à Internet ou d'enregistrements supplémentaires d'un tiers tels que _ga* (Google Analytics), _hjSession* (HotJar) et lms_analytics, AnalyticsSyncHistory (LinkedIn), les informations stockées ou récupérées uniquement à cette fin ne peuvent pas être utilisées pour vous identifier.
Le stockage ou l'accès technique est nécessaire pour créer des profils d'utilisateurs afin d'envoyer de la publicité, ou pour suivre l'utilisateur sur un site web ou sur plusieurs sites web à des fins de marketing similaires. Les cookies utilisés sont rc::* ( Google reCaptcha), _gcl_au, google_adsense_settings ( Google Adsense), _fbc, fbm*, xs, fr, act, _fbp, datr, c_user, sb, *_fbm_ (Facebook), lms_ads, _guid, li-oatml, li_sugr, UserMatchHistory (LinkedIn).